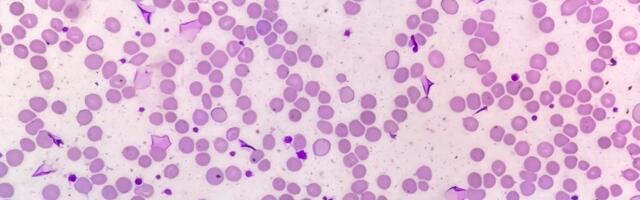
Revolucionarno otkriće: Nova terapija uništila vrstu raka koja je do sada bila neizlečiva

570 mesto 0
Lečenje koje je nekada izgledalo kao nešto iz naučne fantastike sada je uspelo da preokrene tok agresivnih i do tada neizlečivih oblika raka krvi kod pojedinih pacijenata, saopštavaju lekari.
Newsletter svaki dan!
Možete dobiti 10 najvažnijih vesti oko podneva u dnevnom newsletteru. Pritisnite taster i poslaćemo samo najvažnije vesti, bez spama.
LAJKUJ nas na Fejsbuku i neces propustiti najvaznije vesti dana!
Aleksandar Vučić, predsednik Srbije, ponovio je juče da se Ustav neće menjati kako bi on ponovo mogao da se kandiduje za funkciju predsednika države. Ali je ovaj put prvi put naveo uslove pod kojim bi ponovo bio premijer. Pročitaj više ›
2,418
Predsednik Srbije izjavio je juče da se Ustav neće menjati kako bi on mogao ponovo da se kandiduje za funkciju predsednika Republike. „Ovde su ljudi lagali – ‘Vučić će da promeni Ustav, kandidovaće se ponovo’. Ne, naravno da se to neće desiti. Možda ćemo menjati Ustav u vezi sa nekim drugim pitanjima, ali po ovom – to se neće desiti. Bar ne tokom mog mandata“, rekao je Vučić na panelu... Pročitaj više ›
1,651
JOVO BAKIĆ POZIVA NA NASILNO RUŠENJE VLASTI?! "Sasvim sam siguran da se to izborima neće završiti" Nastavlja se blokaderski rat, na meti je ponovo Đilas! Pročitaj više ›
1,569
"Pucaću ti u glavu ako dobijem jedan!": Učenik škole u Beogradu najavio masakr! Uputio jezive pretnje nastavnici, drugarima poručio da će ih zaklati! Pročitaj više ›
1,559
Dragan Đilas, predsednik SSP i narodni poslanik, u odgovoru na tvrdnje sociologa Jove Bakića o koaliciji sa Aleksandrom Vučićem, navodi da je reč o "opoziconaru" koji je svojevremenom izražavao očekivanja da se Vučić neće pokvariti. Pročitaj više ›
1,439
Predsednik Srbije Aleksandar Vučić najavio je da danas ima važan sastanak sa čelnicima EU Ursulom fon der Lajen i Antoniom Kostom u Briselu i dodao da će im predložiti da ceo Zapadni Balakan zajedno prime u EU. Pročitaj više ›
1,400
DEVOJČICU (6) OBLJUBIO MAMIN "DEČKO"?! Teški detalji nezapamćenog zlostavljanja malene iz Kraljeva, evo ko je odmah otišao u policiju Pročitaj više ›
1,382 sveže
Hrvatski Jutarnji list piše da je predsednik Srbije Aleksandar Vučić najavio da će danas u Briselu imati važan sastanak sa liderima EU Ursulom fon der Lajen i Antoniom Kostom, dodajući da će im predložiti da ceo Zapadni Balkan bude primljen u EU zajedno. Pročitaj više ›
963
TEK ŠTO JE IZAŠAO IZ ZATVORA MIŠA BAČULOV PONOVO PRETI: "Nastaviću, ali ne tamo gde sam stao, nego ću da pojačam"! Pročitaj više ›
862
Predsednik Srbije Aleksandar Vučić izjavio je da bi ponovo mogao opet da bude premijer. Pročitaj više ›
828
OVO JE ŽENA KOJA JE PRONAĐENA MRTVA PORED PUTA U SELU KOD NIŠA: Elizabetina misteriozna smrt sve uznemirila! (foto) Pročitaj više ›
804
Andrijana Ofrim (22) poreklom iz Ukrajine, pronađena je mrtva u češkom gradu Fridek-Misteku. Pročitaj više ›
639
Predsednik Srbije Aleksandar Vučić najavio je za četvrtak 11. decembra dolazak u Niš gde će otvotriti dve fabrike Ariston i Palfinger. U trenutku kada strani investitori gase pogone u Nišu ali i širom juga Srbije, predsednik Aleksandar Vučić najavljuje dolazak u Niš u četvrtak, 11. decembra, na nove ceremonije sečenja vrpce – otvaranje Aristona i […] Članak Vučić sutra u Nišu “otvara” dve fabrike se pojavljuje prvo na Naissus.info. Pročitaj više ›
626
Grad Novi Sad raspisaće konkurse za izbor direktora JGSP "Novi Sad" i JKP "Informatika". Pročitaj više ›
578
Lepo ga je videti na terenu! U petak će Partizan dočekati Crvenu zvezdu u okviru prvog ovosezonskog derbija. Igrači oba tima se pripremaju za utakmicu, a jedna zanimljiva scena stiže nam iz Beogradske arene. Прикажи ову објаву у апликацији Instagram Објава коју дели Vladan Tegeltija (@vladan.tegeltija.tegi) Naime, Karlik Džons sa longetom na nozi ... Pročitaj više ›
570 sveže
Na Zimskom prvenstvu Srbije za pionire i kadete, održanom u Novom Sadu, Plivački klub Leskovac predstavile su dve plivačice. Isidora Mitrović nastupila je u disciplini 100 metara prsno i osvojila je srebrnu medalju. Simeona Šparavalo nastupila je u disciplinama 100,200 i 400 metara slobodno. Obe su bile izuzetne i isplivale odlična svoja vremena, ali još veći značaj imala je Isidorina medalja, jer je i na letnjem prvenstvu osvojila srebrnu medalju... Pročitaj više ›
562
Predsednik Republike Srbije Aleksandar Vučić oglasio se putem zvaničnog Instagram naloga uoči posete Briselu. Pročitaj više ›
560
Pokrajinska vlast počela je sa realizacijom svoje "racionalizacije" u okviru koje planira smanjenje broja radnih mesta u administraciji. Ipak, izgleda da se ujedno sklanjaju i nestranački kadrovi. Pročitaj više ›
535 sveže
OPŠTI RAT MEĐU BLOKADERIMA SE NE SMIRUJE! Žestok okršaj Đilasa i Jova Bakića: "Zlonamerno izgovorene laži" (VIDEO) Pročitaj više ›
498 sveže
GOTOVO! PARTIZAN DOBIO NOVOG TRENERA! Crno-beli našli zamenu za Željka Obradovića! Pročitaj više ›
489
Smena policijskih službenika Policijske stanice Palilula nedavno je odbila da obezbeđuje divlje naselje u centru Beograda poznatije i kao ćacilend, saznaje Nova.rs od izvora u MUP-u Srbije. Pročitaj više ›
5,207
Postoji konsenzus među ljudima koji žele promene u Srbiji da će na parlamentarnim izborima podržati studentsku listu "ma ko da je na njoj", ali je politika ograđivanja studenata od onih koji se bore za demokratiju i bolje društvo pogrešna, jer nam je sada potrebna sabornost, kaže Natalija Jovanović, doskorašnja dekanka Filozofskog fakulteta u Nišu. Pročitaj više ›
3,342
Sva istraživanja javnog mnjenja, kao i iskustvo, pokazuju da promene u Srbiji neće biti moguće dok se na izborima catch-all listi vlasti ne suprotstavi catch-all lista prodemokratskih snaga. Pročitaj više ›
1,807
Potpredsednica Stranke slobode i pravde i narodna poslanica Marinika Tepić za Danas kaže da je, prema dokumentaciji koju ona poseduje, pored ministra kulture Nikole Selakovića još šest ministara učestvovalo u nezakonitom oduzimanju statusa kulturnog dobra zgradi Generalštaba. Pročitaj više ›
1,539
Predsednik Srbije Aleksandar Vučić kazao je danas da će vanredni izbori biti održani naredne godine u maju ili decembru. Pročitaj više ›
1,083
Ćacilend nije samo izraz Vučićeve nemoći, već istovremeno sramoćenje Srbije. Te cirkuske šatre ispred predsedništva su do kraja ogolile karakter ove vlasti. 13 godina gledamo cirkuske predstave, a sada je to konačno i otelotvoreno u Ćacilendu, kaže u razgovoru za Danas bivši predsednik Srbije Boris Tadić, sada lider Socijaldemokratske stranke Srbije. Posebno je skandalozno to što svaki put kada režim prikazuje kako su plaćeni ljudi u Ćacilendu životno ugroženi napadima,... Pročitaj više ›
981
Aleksandar Vučić, predsednik Srbije, objavio je na Instagramu, na svom zvaničnom nalogu, snimak kako vozi auto, objašnjavajući da ide da obiđe radove na Ekspu, da je u društvu ministra finansija Siniše Malog, i da će 2026. godine Srbiji biti promenjeno lice. Pročitaj više ›
966
Bogoljub Karić bi, kao svoj najveći doprinos medijskoj sceni u Srbiji, mogao da otkupi Pink i Informer, a onda te televizije da zatvori, odnosno ugasi, ocenjuje za Danas Slobodan Prvanović, naučni saradnik Instituta za fiziku i nekadašnji kandidat za člana Upravnog odbora RTS-a, komentarišući Karićevu najavu da se BK televizija vraća u Srbiju. Pročitaj više ›
947
Niški studenti organizuju protest kojim obeležavaju godinu dana od početka blokade na Filozofskom fakultetu. Studenti iz Sremske Mitrovice krenuli su peške u "Šid", kako bi ga "ponovo oslobodili". Pročitaj više ›
900
Studenti u blokadi su simbolično za kraj godine najavili protest, koji će, prema saznanjima Danasa, biti decentralizovan. Protest je zakazan za 28. decembar, ali i dalje je nejasno koji će fokus protesta biti. Pročitaj više ›
882
Najpopularniji izvori
|
|
21% 10 |
|
|
17% 3 |
|
|
11% 1 |
|
|
10% 2 |
|
|
7% 4 |
| Pogledaj izvore » | |
LAJKUJ nas na Fejsbuku i neces propustiti najvaznije vesti dana!
10.12.2025 14:48
Ažurirano: 14:45.
Pozicija vesti je ažurirana u: 15:42
Šta je Svetionik.com?
Svetionik.com ti donosi najpopularnije vesti sa srpskih news portala u tabeli u realnom vremenu.
Prijatelji sajta
Ocenjivanje slika
Upoznavanje preko Interneta
Prevoz do aerodroma
Honorarni poslovi Beograd
Pročitaj o nama u FAQ sekciji
In another language
Српски / srpski Eesti keel (Eesti uudised) Русский язык (новости Эстонии) Українська мова (новини Естонії)